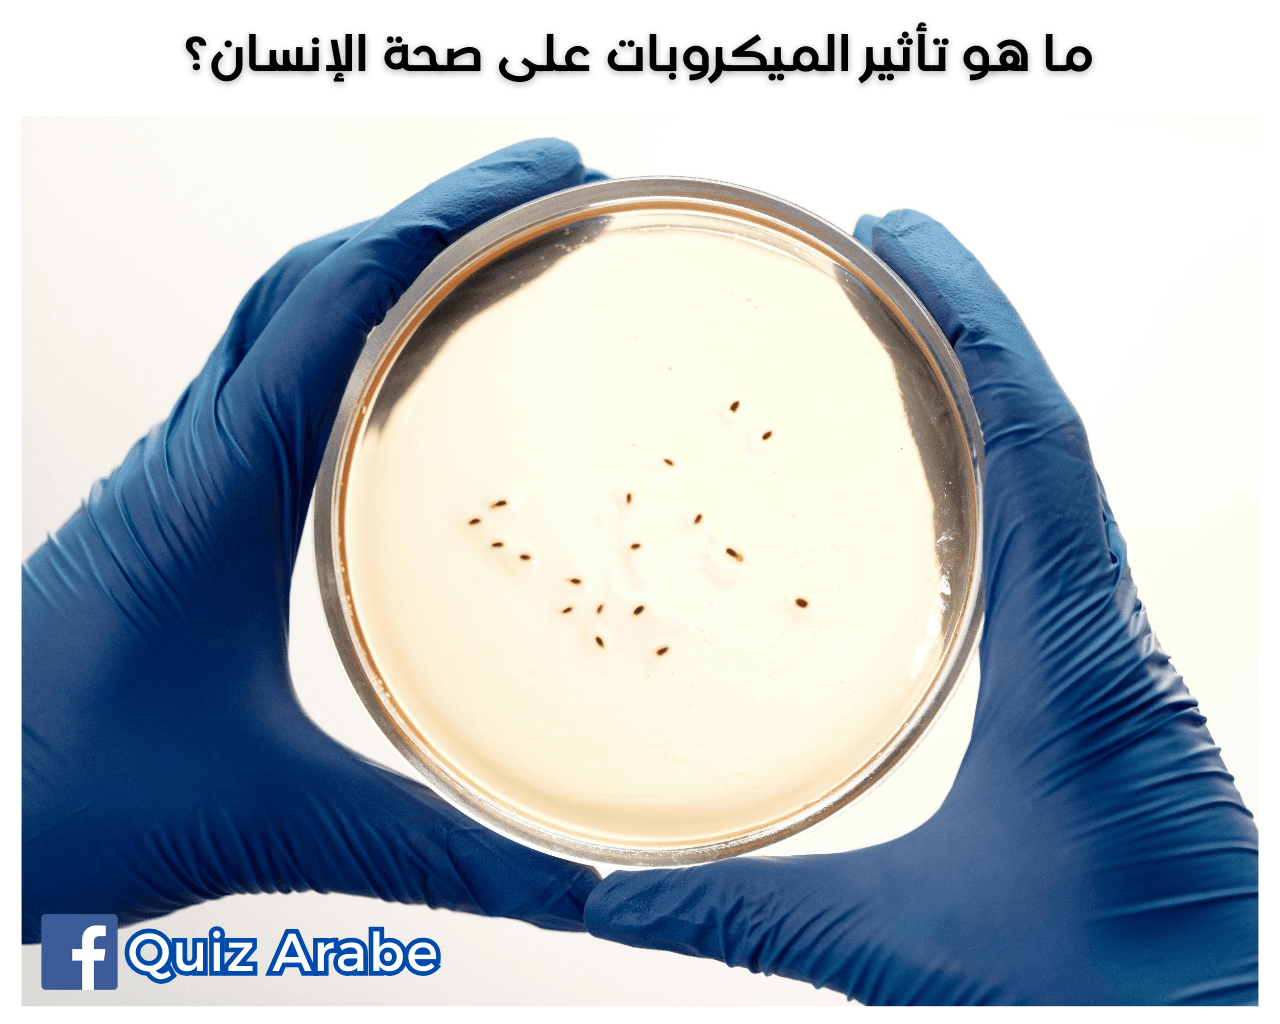
ما هو تأثير الميكروبات على صحة الإنسان

ما هو تأثير الميكروبات على صحة الإنسان
هل تساءلت يومًا "ما هو تأثير الميكروبات على صحة الإنسان"؟ في هذا المقال سنكشف لك الأسرار الخفية لعالم الميكروبات وكيف تؤثر بشكل مباشر على صحتنا الجسدية وعافيتنا النفسية. هل يمكن أن تكون تلك الكائنات الدقيقة التي لا نراها بالعين المجردة هي المفتاح لحياة أكثر صحة؟ دعنا نستكشف هذا الموضوع المثير!
مخطط المقال حول "ما هو تأثير الميكروبات على صحة الإنسان"
القسم الأول: أنواع الميكروبات ودورها في الجسم
- الميكروبات المفيدة
- الميكروبات الضارة
- الميكروبات المتوازنة
القسم الثاني: الميكروبات وصحة الجهاز المناعي
- تعزيز المناعة
- تأثير الميكروبات على الالتهابات
- العلاقة مع الأمراض المناعية
القسم الثالث: تأثير الميكروبات على الصحة العقلية
- الاتصال بين الأمعاء والدماغ
- تأثير الميكروبات على المزاج والسلوك
- دراسات حول الميكروبات والاكتئاب
ما هو تأثير الميكروبات على صحة الإنسان؟
في العالم المايكروسكوبي الذي يزدهر حولنا وداخل أجسادنا، تلعب الميكروبات دوراً مهماً في حياة الإنسان. تعتبر الميكروبات جزءاً لا يتجزأ من بيئتنا البيولوجية، وتأثيرها يتجاوز توقعاتنا بأشواط كثيرة. إن فهم "ما هو تأثير الميكروبات على صحة الإنسان" يعطينا نظرة أعمق حول كيفية تحسين صحتنا ومواجهة الأمراض المختلفة. في هذه المقالة، سنستعرض أنواع الميكروبات ودورها في الجسم، وكيف تساهم في صحة الجهاز المناعي، وتأثيرها على الصحة العقلية.
أنواع الميكروبات ودورها في الجسم
1. الميكروبات المفيدة
الميكروبات المفيدة أو البكتيريا الجيدة تلعب دوراً حيوياً في تعزيز صحتنا العامة. تتواجد هذه الميكروبات في أماكن مختلفة في الجسم مثل الأمعاء والجلد، وتساعد في عمليات هضم الطعام وإنتاج الفيتامينات مثل فيتامين B و K. بالإضافة إلى ذلك، تساهم هذه الكائنات الدقيقة في تعزيز نظام المناعة وحمايته من الالتهابات والأمراض.
2. الميكروبات الضارة
على الجانب الآخر، توجد الميكروبات الضارة التي يمكن أن تسبب الأمراض المختلفة. تشمل هذه المجموعة البكتيريا والفيروسات والطفيليات التي قد تتسبب في عدوى خطيرة إذا لم يتم التحكم فيها بشكل مناسب. التعرف على الميكروبات الضارة والتعامل معها بصورة فعالة يعد جزءاً من التحديات المستمرة في مجال الطب والصحة العامة.
3. الميكروبات المتوازنة
توازن الميكروبات في الجسم هو العامل الأكثر أهمية لصحة جيدة. يشير "ما هو تأثير الميكروبات على صحة الإنسان" إلى أهمية وجود توازن بين الميكروبات المفيدة والضارة في الجسم. ممارسة عادات غذائية صحية وتجنب الاستخدام المفرط للمضادات الحيوية يسهم بشكل كبير في الحفاظ على هذا التوازن الحيوي.
من المهم الإشارة إلى أن البحث المستمر في هذا المجال يمكن أن يقدم لنا حلولاً أكثر فعالية للحفاظ على صحة الإنسان. يمكنك التعرف على المزيد حول كيفية تأثير الميكروبات في جسم الإنسان بزيارة المقالات ذات الصلة على موقع كويز عرب، حيث توجد معلومات قيمة حول العناية بالصحة من خلال الحفاظ على توازن الميكروبات.
للمزيد من المعلومات حول التأثيرات السلبية للميكروبات الضارة، يمكن الاطلاع على صفحة Mayo Clinic حول البكتيريا الضارة أو زيارة موقع WebMD الذي يقدم مقالات وأبحاث موثوقة في هذا المجال.
إن فهم الطبيعة المعقدة للميكروبات وعلاقتها بالصحة العامة يمكن أن يكون المفتاح لتحسين أسلوب حياة صحي ومتوازن، وسنسلط الضوء في الفقرات القادمة على الأبعاد المختلفة لتأثير الميكروبات على الإنسان.
القسم الثاني: الميكروبات وصحة الجهاز المناعي
1. تعزيز المناعة
تلعب الميكروبات دورًا حيويًا في تعزيز الجهاز المناعي، حيث تعمل بعض أنواع الميكروبات المفيدة في الأمعاء على تدريب الجهاز المناعي على التمييز بين الخلايا السليمة والخلايا الدخيلة. هذه العملية تساعد الجسم في رد الفعل السليم تجاه العدوى والفيروسات. فعند المحافظة على توازن الميكروبات في الجسم، نحصل على جهاز مناعي قوي وقادر على مقاومة الأمراض. لمزيد من المعلومات حول كيفية تعزيز الميكروبات للجهاز المناعي، يمكنك زيارة هذا المقال.
2. تأثير الميكروبات على الالتهابات
الميكروبات تُعد لاعبا أساسيًا في العمليات الالتهابية داخل الجسم. الفلورا المعوية المتوازنة يمكن أن تقلل من مستويات الالتهابات المفرطة، حيث تقوم بتحفيز إنتاج المواد المضادة للالتهابات. ومن هذا المنطلق، يصبح الحفاظ على توازن صحي للميكروبات ضروريًا للوقاية من الأمراض المزمنة المرتبطة بالالتهابات المتزايدة. قراءة المزيد في هذا الموضوع.
3. العلاقة مع الأمراض المناعية
إن عدم التوازن في الميكروبات يمكن أن يؤدي إلى تطور بعض الأمراض المناعية، مثل التصلب المتعدد أو داء كرون. الأبحاث تُبين أن استخدام البروبيوتيك والمركبات البريبايوتيكية قد يساهم في إعادة توازن الميكروبات وبالتالي تقليل احتمالية الإصابة بأمراض المناعة الذاتية. الحصول على معلومات إضافية حول تأثير الميكروبات على الأمراض المناعية يمكن الاطلاع عليه في مقال من هيئة الصحة الوطنية.
من خلال الفهم الجيد لـ "ما هو تأثير الميكروبات على صحة الإنسان"، يمكن للأفراد اتخاذ خطوات إيجابية لتحسين توازن الميكروبات في الجسم وبذلك المحافظة على صحتهم العامة وتعزيز مناعتهم باستمرار. للمزيد من التفاصيل حول هذا الموضوع، يمكنك متابعة مجلة Nature التي تقدم دراسات موسعة وموثوقة حول دور الميكروبات في الجسم.
القسم الثالث: تأثير الميكروبات على الصحة العقلية
1. الاتصال بين الأمعاء والدماغ
تشهد الأبحاث العلمية تزايدًا مستمرًا في تناول موضوع الاتصال بين الأمعاء والدماغ، والذي يُعرف أيضًا باسم "محور الأمعاء-الدماغ". يعتبر هذا الاتصال من أهم الاكتشافات الحديثة في ما هو تأثير الميكروبات على صحة الإنسان، حيث تتواجد الميكروبات في الجهاز الهضمي وتلعب دورًا مؤثرًا في التواصل مع الدماغ. تتواصل هذه الميكروبات مع الجهاز العصبي المركزي عبر جهاز معقد من الأعصاب والهرمونات، مما يسهم في تحسين الذاكرة والتركيز وحتى التأثير على الحالة المزاجية للإنسان.
2. تأثير الميكروبات على المزاج والسلوك
يمكن أن تؤثر الميكروبات بشكل مباشر على المزاج والسلوك من خلال إنتاج النواقل العصبية مثل السيروتونين والدوبامين، والتي تعتبر مفتاح التوازن النفسي والعاطفي. هذه المكونات الكيمياوية تؤثر على المشاعر والشعور بالسعادة والرضا. أظهرت دراسات حديثة أن هناك ارتباطاً قوياً بين توازن الميكروبات في الأمعاء وتحسن الصحة النفسية، وهذا يعكس بوضوح ما هو تأثير الميكروبات على صحة الإنسان.
3. دراسات حول الميكروبات والاكتئاب
لقد أصبحت الدراسات الحديثة تزداد توجهاً نحو فهم العلاقة بين الميكروبات والاكتئاب. تشير بعض البحوث إلى أن تغيير نمط حياة الفرد الغذائي وتحسين توازن الميكروبات يمكن أن يكون له تأثير إيجابي على حالة الاكتئاب. في مقالة حول كيفية تأثير النظام الغذائي على صحة الإنسان, تم تسليط الضوء على دور العناصر الغذائية في تحسين الصحة العقلية وزيادة النشاط. يمكن لأي شخص يعاني من الاكتئاب الاستفادة من دراسة هذه التأثيرات والعمل على تحسين توازن الميكروبات لديه كجزء من استراتيجية العلاج الشاملة.
روابط إضافية مفيدة
- للاستفادة من مزيد من المعلومات حول هذا الموضوع، يمكن الاطلاع على هذه الدراسة من PubMed حول ارتباط الأمعاء والدماغ وتأثيرها على الصحة العقلية.
- تحقق من مقال Healthline لمعرفة المزيد عن العوامل التي تؤثر على محور الأمعاء والدماغ ودورها في تعزيز الصحة العقلية.
خاتمة
ما هو تأثير الميكروبات على صحة الإنسان؟ يكمن الحل في فهم تفاصيل هذه العلاقة المعقدة والمهمة. إنها ليست مجرد علاقة لدعم وظائف الحماية والهضم، ولكنها تمتد إلى ما هو أبعد لتحسين الصحة العقلية والجسدية بشكل عام. من خلال تبني نظام غذائي صحي ومتوازن والعناية المستمرة بصحة الجهاز الهضمي، يمكن تحسين الصحة العامة والعيش بحياة أكثر سعادة ورضا.
النداء للعمل
إذا كنت مهتمًا بمعرفة كيف يمكن للميكروبات أن تحسن من حياتك اليومية، نحثك على تجربة نظام غذائي صحي يدعم توازن الميكروبات. شارك تجربتك معنا في التعليقات أو تحدّث عنها على وسائل التواصل الاجتماعي لتلهم الآخرين باتباع أسلوب حياة صحي. لنتبادل الخبرات ولنشهد سويًا كيف يمكن للمعرفة أن تجلب لنا الصحة والسعادة.
نأمل أن يكون هذا المقال قد أضاف إلى معرفتك حول دور الميكروبات في تحسين الصحة العقلية، وندعوك لزيارة موضوعات أخرى مثيرة للاهتمام على موقعنا للغوص في تفاصيل أعمق في هذا العلم الرائع.
FAQ: ما هو تأثير الميكروبات على صحة الإنسان
السؤال 1: ما هي الميكروبات وكيف تؤثر على صحة الإنسان؟
الإجابة: الميكروبات هي كائنات دقيقة تشمل البكتيريا، الفطريات، الفيروسات، والطحالب. بعض هذه الميكروبات تعتبر مفيدة لصحة الإنسان مثل البكتيريا النافعة الموجودة في الجهاز الهضمي، والتي تساعد في هضم الطعام وتحسين امتصاص العناصر الغذائية. بالمقابل، هناك ميكروبات ضارة يمكن أن تسبب أمراضاً مختلفة، مثل الالتهابات المعوية أو الأمراض التنفسية. لذا، تأثير الميكروبات على صحة الإنسان يعتمد على نوع الميكروب وبيئة الجسم.
السؤال 2: كيف تؤثر الميكروبات المفيدة على الجسم؟
الإجابة: الميكروبات المفيدة، مثل بكتيريا البروبيوتيك، تلعب دوراً أساسياً في الحفاظ على صحة الأمعاء. تعمل هذه البكتيريا على تحسين الهضم، تقوية جهاز المناعة، وتقليل خطر الإصابة بالأمراض. كما تساعد في إنتاج الفيتامينات الأساسية، مثل فيتامين B12. تعزيز توازن هذه الميكروبات يمكن أن يساهم في الوقاية من السمنة، السكري، وبعض أنواع السرطان.
السؤال 3: ما هي الأمراض الأكثر شيوعًا التي تسببها الميكروبات الضارة؟
الإجابة: هناك العديد من الأمراض التي تسببها الميكروبات الضارة، ومن بينها:
- الأنفلونزا: فيروس يسبب التهابات في الجهاز التنفسي.
- التهاب الأمعاء: قد يحدث نتيجة عدوى بكتيرية أو فيروسية، مما يؤدي إلى أعراض مثل الإسهال والغثيان.
- التهاب الحلق: عادةً ما يكون ناتجاً عن عدوى بكتيرية أو فيروسية.
- التسمم الغذائي: ينتج عن تناول طعام ملوث بالميكروبات مثل السالمونيلا والإشريكية القولونية (E. coli).
الوقاية من هذه الأمراض تشمل العناية بالنظافة الشخصية والغذائية.
السؤال 4: كيف يمكن تعزيز الميكروبات الصحية في الجسم؟
الإجابة: لتعزيز الميكروبات الصحية، يمكن اتباع عدة خطوات:
- تناول الأطعمة الغنية بالألياف: مثل الفواكه، الخضروات، والحبوب الكاملة، حيث تعمل الألياف على تغذية البكتيريا المفيدة.
- استخدام البروبيوتيك: تناول المكملات الغذائية التي تحتوي على بكتيريا مفيدة، مثل الزبادي المضاف إليه البروبيوتيك أو الأطعمة المخمرة.
- تجنب الإفراط في استخدام المضادات الحيوية: حيث أن هذه الأدوية تقضي على البكتيريا الضارة والمفيدة على حد سواء.
- تقليل التوتر وممارسة الرياضة: فهما يساعدان على تحسين توازن الميكروبات في الأمعاء.
السؤال 5: ما هو دور الميكروبات في جهاز المناعة؟
الإجابة: تلعب الميكروبات دوراً حيوياً في تعزيز جهاز المناعة. حيث أنها تساعد في تشكيل خط الدفاع الأول ضد الميكروبات الضارة. عندما تتواجد الميكروبات النافعة في الجسم، فإنها تنبه جهاز المناعة وتساعده في التعرف على الكائنات الضارة. الميكروبات تساعد أيضاً في إنتاج الأجسام المضادة، مما يزيد من قدرة الجسم على مواجهة الأمراض. وبالتالي، يُعتبر التنوع الصحي في الميكروبات جزءًا مهماً من نظام المناعة الفعال.